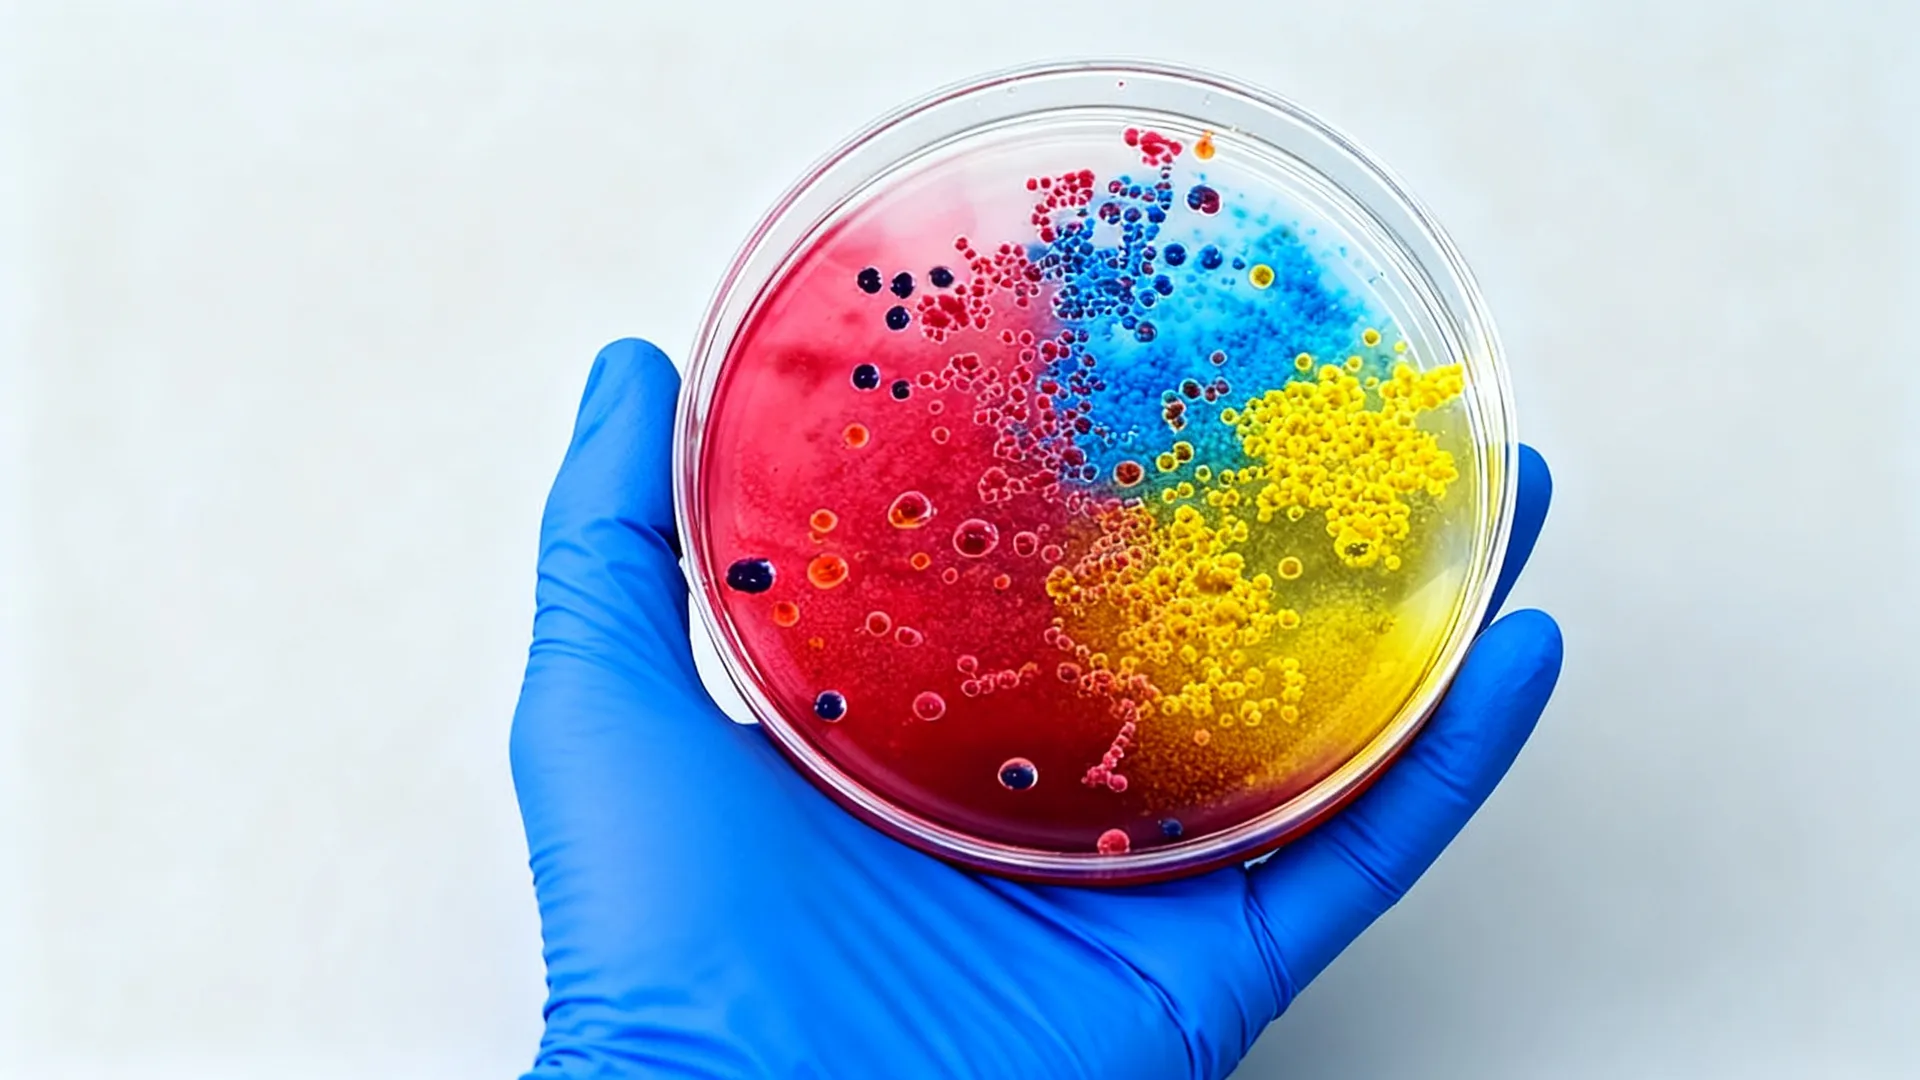
Background 5

❄️ 冬季精选产品
探索我们精选的 ❄️ 冬季精选产品 系列产品。

Cobalt blue CNC finish
Dual-Port Bit Driver
$59

Soft matte with ring LEDs
Analog Audio Control Hub
$79

Soft matte with ring LEDs
Analog Audio Control Hub
$79
☀️ 清凉一夏产品
探索我们精选的 ☀️ 清凉一夏产品 系列产品。

Magnetic knobs, dual input
Modular Synth Box
$149

Transparent shell, neon ring
Compact Action Camera
$189

Beach Ready
Sandals
$45
第三个
探索我们精选的 第三个 系列产品。

Cobalt blue CNC finish
Dual-Port Bit Driver
$59

Soft matte with ring LEDs
Analog Audio Control Hub
$79

Soft matte with ring LEDs
Analog Audio Control Hub
$79
第四个
探索我们精选的 第四个 系列产品。

Magnetic knobs, dual input
Modular Synth Box
$149

Transparent shell, neon ring
Compact Action Camera
$189

Beach Ready
Sandals
$45
第五个
探索我们精选的 第五个 系列产品。

Cobalt blue CNC finish
Dual-Port Bit Driver
$59

Soft matte with ring LEDs
Analog Audio Control Hub
$79

Soft matte with ring LEDs
Analog Audio Control Hub
$79
第六个
探索我们精选的 第六个 系列产品。

Magnetic knobs, dual input
Modular Synth Box
$149

Transparent shell, neon ring
Compact Action Camera
$189

Beach Ready
Sandals
$45